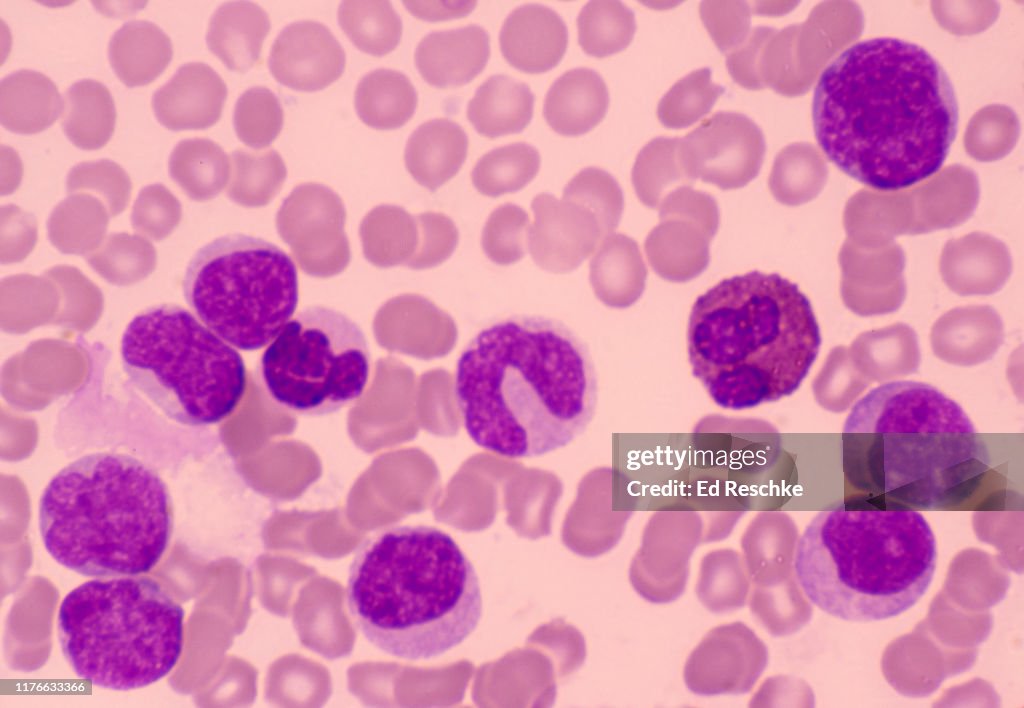
CHRONIC MYLELOGENOUS LEUKEMIA (also called MYELOGENOUS LEUKEMIA) many MYELOBLASTS (Immature white blood cells or leukocytes) 250X

CHRONIC MYLELOGENOUS LEUKEMIA (also called MYELOGENOUS LEUKEMIA) many MYELOBLASTS (Immature white blood cells or leukocytes) 250X - stock photo
CHRONIC MYLELOGENOUS LEUKEMIA (also called MYELOGENOUS LEUKEMIA), many MYELOBLASTS (Immature white blood cells or leukocytes), 250X. This is a human blood smear showing numerous Myeloblasts (immature white blood cells or leukocytes). It also shows an Eosinophil with reddish granules and a bilobed nucleus, and a BAND CELL (near the center, has a horseshoe-shaped nucleus) that develops into a NEUTROPHIL (the most common white blood cell). Large numbers of these is considered abnormal. These cells originate in the red bone marrow (MYELOID tissue), hence the name Myelogenous. Leukemia is a cancer of the blood forming tissues, and involves an abnormal proliferation of white blood, cells (leukocytes), many of which are immature, and do not perform normal functions. This great increase in leukocytes can also crowd out red blood cells and platelets. This image also shows numerous, smaller red blood cells (erythrocytes).
PURCHASE A LICENSE
All Royalty-Free licenses include global use rights, comprehensive protection, simple pricing with volume discounts available
€300.00
EUR
Getty ImagesChronic Mylelogenous Leukemia 250x High-Res Stock Photo
Download premium, authentic CHRONIC MYLELOGENOUS LEUKEMIA (also called MYELOGENOUS LEUKEMIA) many MYELOBLASTS (Immature white blood cells or leukocytes) 250X stock photos from 51³Ô¹ÏÍø Explore similar high-resolution stock photos in our expansive visual catalogue.Product #:1176633366
Download premium, authentic CHRONIC MYLELOGENOUS LEUKEMIA (also called MYELOGENOUS LEUKEMIA) many MYELOBLASTS (Immature white blood cells or leukocytes) 250X stock photos from 51³Ô¹ÏÍø Explore similar high-resolution stock photos in our expansive visual catalogue.Product #:1176633366€300€40
Getty Images
In stockDETAILS
Credit:
51³Ô¹ÏÍø #:
1176633366
License type:
Collection:
Stone
Max file size:
3304 x 2284 px (11.01 x 7.61 in) - 300 dpi - 4 MB
Upload date:
Location:
United States
Release info:
No release required
Categories: